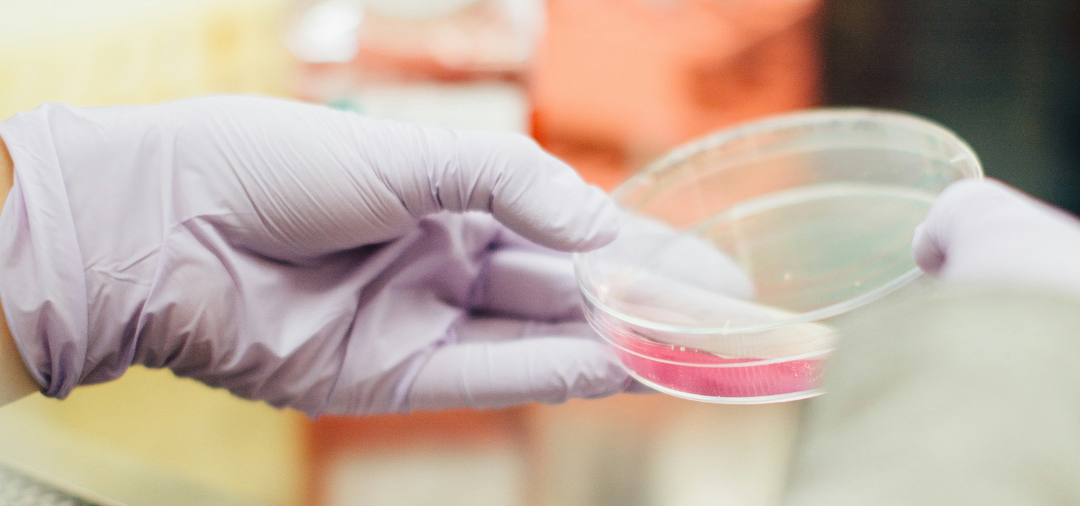

Desde el descubrimiento de la penicilina, los antibióticos han cambiado la medicina en el siglo XX salvando millones de vidas en todo el mundo.
En los últimos años se ha visto un incremento en su consumo, ayudando a erradicar las bacterias perjudiciales y a mejorar la recuperación en diferentes procesos infecciosos. Sin embargo, también pueden destruir ciertas bacterias beneficiosas que se encuentran en nuestro tracto intestinal, lo que denominamos microbiota o flora intestinal.
Esta pérdida de biodiversidad de la microbiota intestinal, conocida como disbiosis, se relaciona con el empeoramiento o desencadenante de diversos problemas digestivos, como la enfermedad de Crohn, la obesidad, el síndrome de intestino irritable… Además se asocia a síntomas como la fatiga, distensión abdominal, diarrea o estreñimiento, ansiedad, entre otros.
¿QUÉ ES LA MICROBIOTA INTESTINAL?
Se estima que la flora intestinal está constituida por 100 billones de bacterias vivas. La flora intestinal colabora con las estructuras del tubo digestivo en las diferentes funciones de nutrición y defensa, ayudando a mantener un buen estado de salud.
Como se mencionó anteriormente, la microbiota intestinal está relacionada con diferentes patologías, por lo tanto, su correcto funcionamiento tiene efecto preventivo contra distintas dolencias comunes en la actualidad.
FUNCIONES METABÓLICAS
La microbiota intestinal produce ácidos grasos de cadena corta de fácil absorción, proporcionando energía para las células de la mucosa intestinal. Además, favorece la absorción de calcio, magnesio y hierro, la producción de vitaminas, como la K, B9 y B12 y la síntesis de aminoácidos.
FUNCIÓN DE DEFENSA
Impiden la implantación y proliferación de bacterias extrañas, ayudando a mantener el equilibrio. También estimula la actividad de las células del sistema inmune.
CONSEJOS PARA CUIDAR LA MICROBIOTA INTESTINAL
A continuación enumeramos tres sencillos consejos que puedes incorporar a tu rutina y que te ayudarán a cuidar y a mantener la biodiversidad de la flora intestinal:
- Tomar prebióticos, que son fibras fermentables que tras llegar al intestino grueso sufren una descomposición por parte de dicha flora, sirviendo de alimento y proporcionando energía y metabolitos. Sería conveniente introducir alimentos de origen vegetal de la forma más variada posible. Además, los polifenoles presentes en los productos vegetales (arándanos, uva, frutas, cacao…) ayudan en la función prebiótica de la fibra, ayudando a la composición y diversidad de la microbiota.
- Realizar actividad física con regularidad aumenta la biodiversidad de bacterias, además de ayudar al correcto funcionamiento gastrointestinal.
- Incorporar probióticos. Por un lado, mediante alimentos fermentados no pasteurizados, ya que contienen microorganismos vivos. Algunos ejemplos son: chucrut, pepinillos, yogur, kéfir, miso. etc. Por otro lado, introducir probióticos comerciales puede ser una buena opción para proteger la microbiota, ya que aportan cantidades más altas proporcionando así mayor protección, sobre todo cuando se recetan antibióticos.

NUESTROS SUPLEMENTOS
Desde Nutralie te recomendamos nuestros suplementos Biprotics Complex y Biprotics 30 Strains Complex.
Para mantener tu salud digestiva y prevenir problemas de salud, Biprotics Complex contiene 10 cepas diferentes, con un total de 50 mil millones de unidades formadoras de colonias.
Si en cambio necesitas fortalecer la barrera intestinal y repoblar tras tomar un tratamiento antibiótico, Biprotics 30 Strains Complex, contiene 30 cepas diferentes, con un total de 132 mil millones de unidades formadoras de colonias, además de fibra prebiótica y micronutrientes, que ayudan a modular la respuesta inmune.